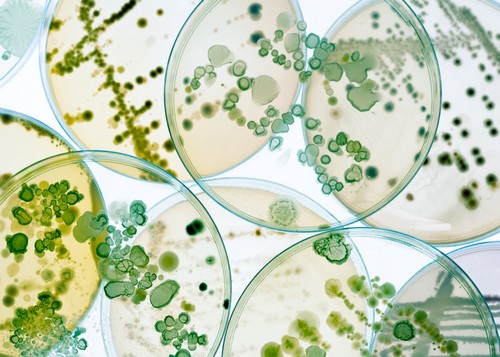
Na zdrowie

Seria łączy klasyczną wysokość brodzika (12 cm) ze współczesnym trendem płytkości (2,5 cm). Dzięki zastosowaniu technologii Stabilsound Plus® oraz zintegrowanym – przeciągniętym frontowym panelem montaż jest niebywale prosty, czysty i szybki. Zastosowana w serii technologia niesie ze sobą także wiele innych korzyści użytkowych.
- Poznaj technologię komfortu.1.Pożegnaj brud i bakterie – łatwa do czyszczenia powierzchnia (Easy to Clean) posiada także właściwości antybakteryjne (Antibac®)
2.Wielowarstwowe wzmocnienia – zwiększona wytrzymałość także na newralgicznych rantach brodzika i wypełnienie izolujące
3.Stabilność i bezpieczeństwo – konstrukcja stabilizująca zapewnia bezpieczne korzystanie i pełne podparcie.
4.Przemyślany układ odpływowy – prosta aranżacja całego układu rur odpływowych i syfonu dzięki fabrycznym kanałom wewnątrz konstrukcji
5.Bok brodzika przygotowany do bezpośredniego oklejania płytkami lub zintegrowany panel boczny![Poznaj technologię komfortu.]()
- Na zdrowieDzięki powłoce Antibac® masz pewność, że na powierzchni brodzika nie rozwiną się żadne bakterie.
![Na zdrowie]()
- Odporność na upadkiMateriał Stonicryl® i technologia Stabilsound Plus® gwarantują wytrzymałość i odporność brodzika na wszelkie uderzenia, upadki czy wysoki nacisk.
![Odporność na upadki]()
- Ciesz się cisząCichy prysznic o każdej porze, bez budzenia domowników, dzięki naszym rozwiązaniom akustycznym.
![Ciesz się ciszą]()
- Z naciskiem na wytrzymałość!Dzięki zastosowaniu technologii Stabilsound Plus®, nasz brodzik jest w stanie wytrzymać jeszcze większy nacisk.
![Z naciskiem na wytrzymałość!]()
- Postaw na komfort!Użyliśmy specjalnych materiałów izolujących, dzięki którym nie musisz przejmować się zimną powierzchnią brodzika. Takie rozwiązanie to nie tylko korzyści wygłuszające i izolacyjne, ale przede wszystkim pełen komfort.
![Postaw na komfort!]()
- Montaż jak z bajkiPrzy projektowaniu brodzika kierowaliśmy się tym, aby jego montaż był jak najprostszy. Poprzez wyeliminowanie konieczności używania kotw przyściennych z łatwością go zamontujesz.
![Montaż jak z bajki]()
- Słychać tylko Twój śpiew40% - o tyle procent użyte przez nas materiały i komponenty tłumią hałas spadającej wody podczas kąpieli. Pożegnaj się z irytującymi dźwiękami i ciesz się spokojem.
![Słychać tylko Twój śpiew]()







 Najtańsza dostawa:
Najtańsza dostawa: